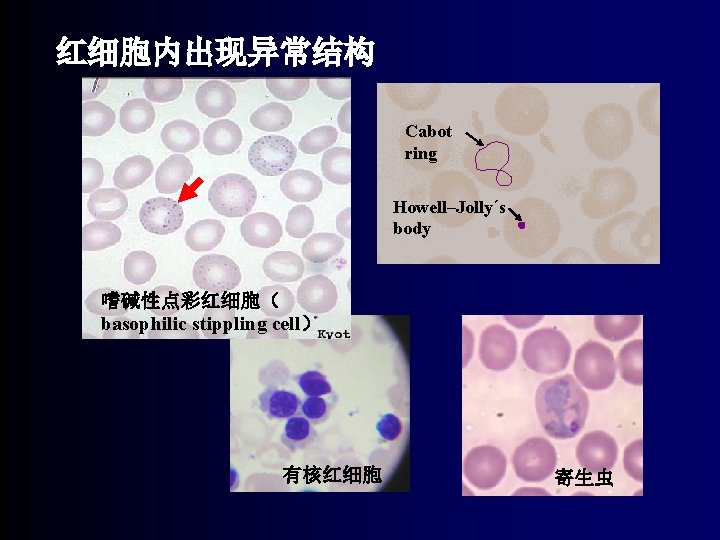
红细胞内出现异常结构 Cabot ring Howell–Jollyˊs body 嗜碱性点彩红细胞（ basophilic stippling cell） 有核红细胞 寄生虫
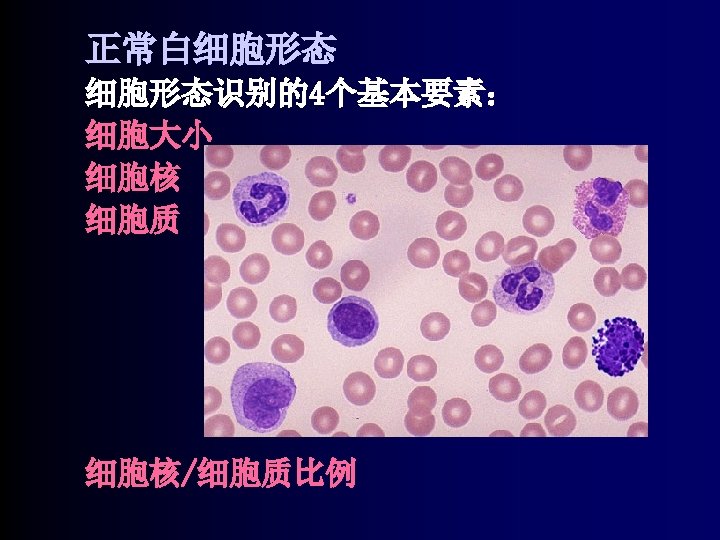

laboratory diagnostics RBC hematocyte 45 WBC blood platelet

实验诊断学 laboratory diagnostics


RBC hematocyte (45%) WBC blood platelet neutrophil eosinophil basophil monocyte lymphocyte Fg plasma (55%) serum water solid element

1. 外周血计数blood cell count • 红细胞计数erythrocyte count 方法method 正常参考值reference interval 临床意义clinical significance • 白细胞计数leukocyte count • 血小板计数platelet count • 网织红细胞计数reticulocyte count


Neubauer计数盘

3 mm WBC WBC 1 mm 计算:WBC/L=N/4× 106× 20

(2)自动血液分析仪automated hematology analyzer, AHA • 电阻抗法血细胞分析仪的原理 principal of coulter hematology ststem • 直方图histogram











2. 血红蛋白测定 determining the concentration of hemoglobin • 方法method 氰化高铁血红蛋白法 hemiglobincyanide (Hi. CN)method Hemoglobin Structure

THE NORMAL HUMAN HEMOGLOBENS Hemoglobin Globin Chains Major Source Embryo Neonate Adult % % % Gower 1 ζ 2/ε 2 Yolk sac 50 0 0 Gower 2 α 2/ε 2 Yolk sac 25 0 0 Portland ζ 2/γ 2 Yolk sac 25 0 0 Hb F α 2/Gγ 2 a Liver, spleen 0 75 < 1 α 2/Aγ 2 Hba α 2/β 2 Bone marrow 0 25 97 Hb. A 2 α 2/δ 2 Bone marrow 0 < 1 3


3. 红细胞比容 hematocrit(packed cell volume) definition: Relative volume of blood occupied by erythrocytes. An average figure for humans is 45 per cent, i. e. A packed red cell volume of 45 ml in 100 ml of blood. layer after blood centrifuged

Hematocrit ®手 法 Centrifuging Hematocrit is % of total volume made of cells ®AHA HCT=RBC×MCV 参考范围: 微量法:男性 0. 47± 0. 04 女性 0. 42± 0. 05 临床意义: 用于判断贫血及计算红细胞 3个平均指数

4. 红细胞三个平均指数 erythrocyte indices • Mean corpuscular volume MCV=Hct× 103× 1012/RBC (f. L) 正常参考值: 80~90 f. L • mean corpuscular hemoglobin MCH=Hb× 1012/RBC(Pg) 正常参考值: 27~32 Pg • mena corpuscular hemoglobin concentration MCHC=Hb/Hct 正常参考值: 320~360












8、血涂片检查blood film examination 标本的制备making and staining blood film 手 推片法: 血量少、操作简单、重复差。


• 观察红细胞的形态及分布 obseve erythrocyte form and distribution • 观察白细胞形态observe leukocyte form • 观察血小板的形态observe platelet form • 观察有无寄生虫observe parasite

u观察红细胞 正常红细胞normal erythrocyte observe erythrocyte • • 色素colour 大小size 形态shape 异常结构abnormal structure red cell observed under electric microscope

红细胞内出现异常结构 Cabot ring Howell–Jollyˊs body 嗜碱性点彩红细胞( basophilic stippling cell) 有核红细胞 寄生虫

u观察白细胞observe leukocyte • 白细胞分类计数differential leukocyte count • 异常白细胞abnormal white cell 嗜中性粒细胞的核象变化:

(3)浆细胞(plasma cell): Mott细胞(Mott cell) 火焰状浆细胞 (flame cell) Russell小体 (Russell body)

参考书籍 l《实验诊断学》英文版 人民卫生出版社 主编 王鸿利 l《Dacie and Lewis PRACRICAL HAEMATOLOGY》 TENTH EDITION l《Clinical Laboratory Medicine》 Kenneth D. Mc. Clatchey

- Slides: 56